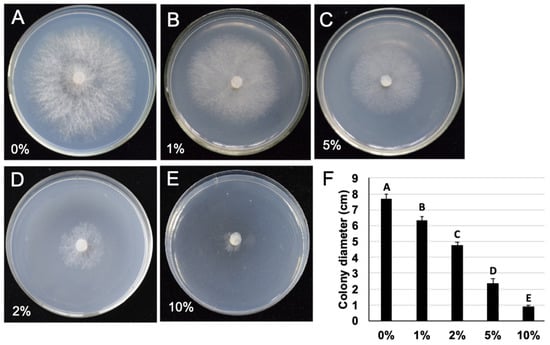

Abstract
Gray mold disease caused by Botrytis cinerea is a devastating disease that leads to serious financial loss. In this study, the entomopathogenic fungus Metarhizium anisopliae that acts against the gray mold pathogen B. cinerea was evaluated. M. anisopliae produced a significant inhibition zone in front of the B. cinerea colony in the dual culture test. In addition, volatile organic compounds generated by M. anisopliae were shown to have an inhibitory effect on B. cinerea mycelia growth and reduced 41% of gray mold severity of postharvest tomatoes. The 10% concentration of the culture filtrate of M. anisopliae inhibited 88.62% of colony radial growth as well as 63.85% of sclerotia germination and all conidia germination of B. cinerea. Furthermore, the culture filtrate of M. anisopliae retained its inhibitory effect against the radial growth of B. cinerea even after heating for 15 min at 100 °C. Feasible mechanisms of M. anisopliae involved in the control of B. cinerea were explored, and it was demonstrated that the plasma membrane of B. cinerea conidia was damaged by the product of metabolism of M. anisopliae. In addition, after treating with culture filtrate of M. anisopliae, the B. cinerea phenotype was shown to be abnormal, and cell organelles of B. cinerea mycelia were damaged significantly. A significant control efficacy of M. anisopliae against tomato gray mold was detected on both the detached leaf assay (84.24%) as well as the whole plant (72.38%). In addition, a 78% reduction in tomato fruit mold was detected at a 10% treated concentration of M. anisopliae. These findings suggest that M. anisopliae possesses potential as a biocontrol agent against tomato gray mold in the greenhouse and during the postharvest stage.
1. Introduction
The phytopathogenic fungus Botrytis cinerea Pers. has a broad range of hosts including more than 200 crop species, causing gray mold [1]. It causes serious pre- as well as postharvest diseases in many economically important crops, such as tomato, strawberry, pear, cherry, eggplant, grape, and peppers. [2,3]. Among them, tomato gray mold is a devastating disease that causes serious financial losses worldwide [4,5]. The pathogen can infect tomato fruits and each part of the tomato plant either by injury after pruning and harvesting or direct penetration [6]. It also produces characteristic symptoms under favorable conditions, especially at low temperatures (10 to 25 °C) coupled with humid conditions [7]. Generally, the symptoms of the disease become visible later than host infection because the pathogen remains dormant for a long time inside the host. This pathogen also can survive in crop debris after the growing season as a mycelium along with or without conidia or sclerotia [8]. Furthermore, the resistant germplasm and resistance variety of tomato gray mold disease have not been screened worldwide. Therefore, it is tough to control gray mold disease of tomatoes.
Over previous decades, the control of B. cinerea has depended mainly on chemical fungicides [9]. However, evidence reveals that B. cinerea has developed certain resistance to many fungicides, including anilinopyrimidines dicarboximides, benzamide, fenhexamid, diethofencarb, procymidone, pyrimethanil, and hydroxyanilide [10,11,12]. Furthermore, a B. cinerea strain has multiple types of fungicide resistance that can be found in cropland [13]. To date, abuse and excessive use of fungicides have caused environmental pollution and disruption of ecological ecosystems, as well as pose a danger to human health due to the high residual fungicides effect in tomato fruit [14,15]. Hence, there is an urgent demand for substitute measures that could safely and efficiently control tomato gray mold. Biological control is undoubtably a good option. Generally, microbial bioagents, for example, fungi, bacteria, and yeast, can effectively manage plant diseases through antibiosis [16,17,18], competition for places and nutrients, volatile compounds [19,20], parasitism [21], and initiation of plant defense [22].
M. anisopliae is a widely distributed entomopathogenic fungus with immense efficacy against various insect pests such as locusts, thrips, whiteflies, and ticks [23,24,25,26]. Recently, Meterhizium spp. also showed multifarious roles in the ecosystem as endophytes, plant growth promoters, and antagonists of plant pathogens [27]. M. anisopliae revealed differential expression of genes encoding hydrolytic enzymes, antimicrobial peptides, toxins, cell wall proteins, as well as other molecules [28]. Secondary metabolites generated by this fungus exhibit various insecticidal, anticancer, antioxidant, and antimicrobial properties. They have also been suggested as potential substitutes for the improvement of new bioactive agents [29,30]. If a fungal strain retains dual actions against insect pests and also plant pathogens, this would be a potent advantage for crop protection. Hence, the entomopathogenic fungus in the current study, M. anisopliae, was inspected for their antifungal activities against B. cinerea.
Few previous studies have presented the inhibitory effect of M. anisopliae on B. cinerea [31,32]. However, the in vivo biocontrol efficiency and possible mechanism of the inhibition process is still unknown. The present study assessed the antagonistic effects of M. anisopliae on B. cinerea using culture filtrate, crude extract, and volatile organic compounds (VOCs), as well as exploring the mechanisms of inhibition. In addition, the efficacy of M. anisopliae was evaluated for disease severity reduction by assessing on detached leaves, whole tomato plants, as well as ripe fruits after harvesting. Overall, this study showed that M. anisopliae could be a potential biocontrol agent against tomato gray mold disease introduced by B. cinerea during the plant growth stage and fruit storage period. In this context, the present study aims to determine the antifungal activity of M. anisopliae against B. cinerea under in vitro and in vivo conditions and to explore possible mechanisms of biocontrol.
2. Results
2.1. The Antagonism of M. anisopliae against to B. cinerea
Antagonistic assessment results showed that M. anisopliae has potential activity against B. cinerea. M. anisopliae produced a clear inhibition zone ahead of the B. cinerea colony (Figure 1). The average width of the inhibition zone was about 6.3 mm between two colonies, and M. anisopliae inhibited about 43.9% of B. cinerea radial growth as compared with the control. In addition, B. cinerea showed excessive twisted hyphal branching when inhibited by M. anisopliae. This indicates the existence of fungistatic secondary metabolites produced by M. anisopliae.

Figure 1.
Inhibitory effect of M. anisopliae against B. cinerea in dual culture on potato dextrose agar. (A) Pure culture of B. cinerea, 20 °C, 4 dpi; (B) dual culture of M. anisopliae and B. cinerea showing inhibition zone between two colonies, 20 °C, 4 dpi.
2.2. The M. anisopliae Culture Filtrate Influenced the Growth and Morphology of B. cinerea
B. cinerea was cultured on potato dextrose agar (PDA) with added culture filtrate of M. anisopliae, and PDA plus potato dextrose broth (PDB) was used as the control. The colonies grown on PDA that amended 5% (v/v) culture filtrate were significantly smaller as compared with colonies grown on PDA (Figure 2A,D). Microscopic observation showed the mycelia of B. cinerea were vigorous, whereas culture filtrate treatment led the mycelia of B. cinerea with more short branches (Figure 2B,E). Transmission electron microscopy (TEM) observation exhibited that B. cinerea possess the normal structure of cell components in control treatments and intact and well-preserved cell walls, obvious nucleus, and mitochondria were frequently visible in the cells (Figure 2G). However, after treated with culture filtrate of M. anisopliae (5%, v/v), cell organelles were seriously damaged (Figure 2H). In addition, no sclerotium was observed at 21 dpi after treating B. cinerea with 5% (v/v) culture filtrate of M. anisopliae (Figure 2C,F). This suggests that the metabolites of M. anisopliae are able to suppress the mycelium growth and sclerotium formation of B. cinerea.

Figure 2.
Inhibition activity of M. anisopliae culture filtrate on B. cinerea growth. (A–C) The normal phenotype of B. cinerea on potato dextrose agar (PDA); (D–F) abnormal growth of B. cinerea on PDA amended with 5% (v/v) culture filtrate of M. anisopliae. (A,C) colony of B. cinerea at 20 °C, 4 dpi; (B,E) hyphal tips of B. cinerea; (G,H) transmission electron microscopy (TEM) photos of the cells of B. cinerea mycelia. N represents the nucleus; W represents the cell wall. (D,H) colony of B. cinerea at 20 °C, 21 dpi; the arrow points to the sclerotium.
The inhibition rates of M. anisopliae culture filtrate to B. cinerea significantly (P < 0.01) increased with an increase in concentration of M. anisopliae culture filtrates (Figure 3). Among the tested concentrations of culture filtrate, culture filtrate at a concentration of 10% showed 86.7% growth inhibition to B. cinerea, and an inhibition rate of 68.9% was recorded when treated with culture filtrate at a concentration of 5%. Eventually, culture filtrate at a concentration of 1% showed an inhibitory rate of 19.42% to B. cinerea radial growth.
Figure 3.
(A–E) colony of B. cinerea on PDA added to 0%, 1%, 2%, 5%, and 10% culture filtrates of M. anisopliae, 20 °C, 4 dpi; (F) colony diameter of B. cinerea on PDA added with different concentrations of culture filtrate, 20 °C, 4 dpi.
2.3. The Culture Filtrate of M. anisopliae Affected the Sclerotia Germination of B. cinerea
Sclerotia that can survive in unfavorable environmental conditions are a resting form of B. cinerea; thus, we tested the influence of M. anisopliae on B. cinerea sclerotia germination. The sclerotia germination rate was 35.04% in the group treated with 10% culture filtrate, while the germination rate was 96.89% in the untreated control group (Table 1). The results showed that the inhibition rate of 10% culture filtrate to sclerotia germination reached 63.85%. This demonstrates that the culture filtrate of M. anisopliae can suppress the sclerotia germination of B. cinerea.

Table 1.
Effect of culture filtrate of M. anisopliae on B. cinerea sclerotia germination.
2.4. The Culture Filtrate of M. anisopliae Inhibited Conidia Germination of B. cinerea
Conidia are primary sources of infection for gray mold occurrence. Hence, examining the culture filtrate effect on the germination of conidia can directly verify whether the plant disease can develop and prevail. Therefore, to assess the antifungal efficacy of M. anisopliae to B. cinerea conidia, we evaluated conidia germination, as well as germ tube expansion of B. cinerea using four concentrations of M. anisopliae culture filtrate. All of the tested concentrations of culture filtrate significantly inhibited conidia germination, and the inhibition of conidia germination positively interacted with the culture filtrate concentration. The conidia germination percentage was above 90% in the control at 8 hpi (Figure 4A), while approximately 4.2% of conidia germinated in 1% culture filtrate at 8 hpi, and the germ tube length (average 5.8 µm) of the germinated conidia was much shorter than that of the control B. cinerea (average 25.4 µm) (Figure 4B). Notably, no geminated conidia were detected (100% inhibition) in 2% to 10% culture filtrate at 8 hpi (Figure 4C). This suggests that M. anisopliae culture filtrate plays a vital role in inhibiting conidia germination, as well as influencing the germ tube length of B. cinerea.

Figure 4.
Effect of culture filtrate of M. anisopliae on the germination of conidia. (A–C) B. cinerea conidia were incubated in sterile water, 1% culture filtrate, and 10% culture filtrate for 8 h, respectively; (D,E) B. cinerea conidia was incubated in sterile water for 8 h and then stained by propidium iodide; (F,G) B. cinerea conidia was incubated in 10% culture filtrate of M. anisopliae for 8 h, and then stained by propidium iodide; (H) the percentage of plasma membrane damaged conidia after treatment with culture filtrate of M. anisopliae.
To examine the possible mechanisms of M. anisopliae culture filtrate that show conidia germination inhibition, the condition of the plasma membrane of B. cinerea conidia was inspected (Figure 4D–H). The plasma membranes damaged conidia discharged red fluorescence beneath the fluorescence microscope, whereas no fluorescence could be distinguished from conidia with undamaged plasma membranes (Figure 4D–G). The 10% culture filtrate of M. anisopliae showed 74% damage of the plasma membrane integrity of B. cinerea conidia at 8 hpi as compared with a water control. Meanwhile, the membrane veracity of conidia declined rapidly with an increased incubation period (Figure 4H).
2.5. The Antifungal Substance Produced by M. anisopliae Retains Its Activity at High Temperatures
The culture filtrate of M. anisopliae was heated to 40, 60, 80, and 100 °C. Then, B. cinerea was cultured on PDA added heat-treated or non-treated culture filtrate and incubated at 20 °C for 4 days. The heat-treated and non-treated culture filtrates of M. anisopliae exhibited parallel inhibitory effects on B. cinerea growth, and no significant differences were observed among the treatments (Figure 5). The inhibition effect of 5% non-heated culture filtrate showed 68.65% growth inhibition, as well as 69.1%, 68.31%, 67.4%, and 66.1% growth inhibition when the culture filtrate was heated to 40, 60, 80, and 100 °C, respectively (Figure 5). This shows that the antifungal substance produced by M. anisopliae is able to retains its activity at high temperatures.

Figure 5.
Effect of heating on the antifungal activity of culture filtrate of M. anisopliae against B. cinerea growth. Bars with the same letters are not statistically significant based on the least significant difference (LSD) test (P < 0.01).
2.6. The Culture Filtrate of M. anisopliae Reduced the Gray Mold Severity of Detached Leaves and Fruits of the Tomato
Detached tomato leaves soaked in sterile water, as well as culture filtrate and inoculated with conidia of B. cinerea, exhibited typical lesions (Figure 6A,B). The lesion area of B. cinerea on leaves soaked in sterile distilled water was about 2.7 cm at 4 dpi, whereas 10% M. anisopliae culture filtrate treatment showed lesions with a diameter of 0.4 cm (Figure 6C). The potential of M. anisopliae to control gray mold was also tested on tomato fruits (Figure 6D–F). No lesions were observed when tomato fruits were inoculated with only culture filtrate of M. anisopliae (Figure 6F), whereas 4 days after inoculation with B. cinerea conidia, the lesion diameter on culture filtrate treated tomato fruits was 0.7 cm, which was only lower than B. cinerea conidia treated fruits with a lesion diameter of 3.0 cm (Figure 6G). This suggests that M. anisopliae significantly reduced the lesions caused by B. cinerea on both leaves and fruits. Furthermore, the biocontrol potentiality of culture filtrate was evaluated on whole plants (Figure 6H–P). The biocontrol efficiency was shown to be 72.38% and 63.19% when plants were treated with a 10% dilution of M. anisopliae culture filtrate against 1 × 106 conidia/mL and 5 × 106 conidia/mL of B. cinerea as compared with the control. Moreover, when plants were inoculated with only B. cinerea spores, plants inoculated with 5 × 106 conidia/mL showed significantly more leaf lesions as compared with those inoculated with 1 × 106 spore/mL (Figure 6L,N).

Figure 6.
Control of B. cinerea on detached tomato leaves, fruits, and whole plants. (A–C) Effect of M. anisopliae culture filtrate on disease severity caused by B. cinerea, 4 dpi, 20 °C. Gray mold severity on detached tomato leaves treated with (A) sterile water and (B) culture filtrate of M. anisopliae, (C) lesion diameter on detached leaves; (D–G) efficacy of M. anisopliae culture filtrate on tomato fruit mold caused by B. cinerea. (D) treated with PDB and conidia of B. cinerea as a control, (E) tomato treated with culture filtrate of M. anisopliae and conidia of B. cinerea, and (F) tomato treated with culture filtrate only; (G) lesion diameter on tomato fruits; (H–O) disease symptoms caused by B. cinerea on whole tomato plants, 4 dpi, 20 °C. (H,L) tomatoes inoculated with 1 × 106 conidia/mL conidia suspension of B. cinerea, (I,M) tomatoes treated with 1 × 106 conidia/mL conidia suspension of B. cinerea and culture filtrate of M. anisopliae; (J,N) tomatoes inoculated with 5 × 106 conidia/mL conidia suspension of B. cinerea; (K,O) tomatoes treated with 5 × 106 conidia/mL conidia suspension of B. cinerea and culture filtrate of M. anisopliae; (P) lesion diameter on leaves of whole plants. Bars with the same letters are not statistically significant based on the LSD test (P < 0.01).
2.7. The Volatile Organic Compounds of M. anisopliae Reduced the Gray Mold Severity of Postharvest Tomatoes
The impact of volatile organic compounds produced by M. anisopliae against the radial growth of B. cinerea was checked based on the double-plate chamber method. The results showed that volatile organic compounds produced by M. anisopliae inhibited about 42.6% of B. cinerea radial growth at 4 days post combined culture (Figure 7A–C). In addition, the volatile organic compounds (VOCs) of M. anisopliae reduced the gray mold severity of postharvest tomato by about 41.16% (Figure 7D–F). An average lesion size of 2.1 cm on tomato fruit treated with volatile organic compounds was shown at 4 dpi, while a lesion size of 3.6 cm was recorded in control fruits. Therefore, volatile organic compounds of M. anisopliae have the ability to protect postharvest tomatoes against B. cinerea.

Figure 7.
Effect of volatile organic compounds of M. anisopliae on B. cinerea. (A–C) Effect of volatile organic compounds of M. anisopliae on the growth of B. cinerea on PDA, 20 °C, 4 dpi. (A) normal colony growth of B. cinerea, (B) growth inhibition by volatile organic compounds of M. anisopliae, and (C) colony diameter of B. cinerea; (D–F) the potential of volatile organic compounds of M. anisopliae to act on postharvest tomato. (D) tomato fruits treated with sterile water, (E) tomato fruits treated with volatile organic compounds of M. anisopliae, and (F) lesion diameter of volatile organic compounds on treated and untreated tomatoes. Bars with the same letters are not statistically significant based on the LSD test (P < 0.01).
3. Discussion
B. cinerea is among the top 10 fungal pathogens. Fungicide application remains the most common method to control B. cinerea, and fungicides specifically targeted against Botrytis (“botryticides”) represent 10% of the world fungicide market [33]. Fungicide residues lead to risks of environmental pollution and the appearance of multiple fungicide-resistant B. cinerea strains [10,11,12]. Some beneficial microorganisms are able to inhibit gray tomato mold, such as Trichoderma, Bacillus, and Ulocladium [34,35], and these could be developed as new biocontrol agents to reduce the use of synthetic fungicides. In the present study, the biocontrol potentiality of M. anisopliae strain IBCCM321.93 against gray mold was evaluated. To our knowledge, no previous information is available about the biocontrol efficacy of M. anisopliae against gray mold of tomato plants in green houses or mold of postharvest tomato fruits.
In a previous report, M. anisopliae strain SD3 produced am inhibition zone in front of B. cinerea colony of only about 1 mm [31]. In contrast, M. anisopliae strain IBCCM321.93, which was used in this study, was able to produce an inhibition zone of about 6.3 mm in front of B. cinerea. It is suggested that M. anisopliae strains have diverse biological characteristics and different levels of biocontrol potential. We found that, in addition to inhibiting mycelium growth, the culture filtrate of M. anisopliae strain IBCCM321.93 can suppress sclerotia formation and germination, as well as conidia germination. Both sclerotia and conidia play essential roles in disease development in B. cinerea. The sclerotia of B. cinerea can survive under adverse environmental conditions for a long time without a host, and conidia are a vital source of primary infection for the development of gray mold diseases [33]. Thus, it is possible to control B. cinerea by affecting the formation or survival of sclerotia or conidia. Hence, we conclude that M. anisopliae may be highly effective for controlling B. cinerea. This hypothesis was confirmed by the application of M. anisopliae on tomato plants and fruits. We found the cultural filtrate of M. anisopliae performs biocontrol efficacy against gray mold on detached tomato leaves, whole plants, as well as postharvested tomato fruits. However, the preventive control effect of culture filtrate of M. anisopliae against gray mold of tomato is still unknow. It could be evaluated in future by treating plants with culture filtrate before plants are infected naturally by B. cinerea. It has been reported that M. anisopliae is capable of endophytic colonization on the roots of plants, thereby enhancing plant growth and acting as a plant disease antagonist [36]. The M. anisopliae agent used in this study was culture filtrate, suggesting that the mechanism of M. anisopliae that controls B. cinerea possibly depends on secondary metabolites other than endophytic colonization.
The influence of the cultural filtrate of M. anisopliae on B. cinerea was observed in this study. Transmission electron microscopy showed that the cell organelles of B. cinerea mycelia treated with M. anisopliae culture filtrate were seriously damaged, suggesting that M. anisopliae produces some active substance with toxicity action against B. cinerea. In addition, based on fluorescence emissions from conidia treated with propidium iodide, it is assumed that some secondary metabolites generated by M. anisopliae also play a role in damaging the plasma membrane integrity of conidia. Therefore, we assume that the damage of cell organelles and plasma membrane could be the main method by which M. anisopliae suppresses the normal development of B. cinerea. In a previous report, several mechanisms were investigated to describe the mode of action accountable for the insecticide activity of M. anisopliae. It was stated that the secretion of protease, chitinase, and lipases by M. anisopliae are associated with the process of infection [37]. These enzymes are considered to assist host tissue penetration by degrading the host’s exterior layers (cuticles of nematode, insects, and cell wall of fungi) or utilizing the host’s proteins for nutrition [38]. For example, previous studies reported that chitinase from Trichoderma harzianum and Clonostachys rosea enhanced the inhibition of B. cinerea [39,40,41,42]. In this study, the antifungal substance produced by M. anisopliae retained its activity after high-temperature treatment, suggesting that the main part of the antifungal substances are probably not proteins. This property of the antifungal substance indicates that the biocontrol agent produced by M. anisopliae can be stocked at room temperature. In addition, it can ensure the stability of biocontrol agents under high temperatures, such as in summer. Therefore, this feature can reduce the storage cost and expand the application area of the biocontrol agent. It has been reported that M. anisopliae also produces secondary metabolites, such as destruxins, swainsonine, and polyketides [43]. Whether these or some other new substances play roles in the inhibition of B. cinerea still requires study. Cultural filtrate has antimicrobial activity. To our knowledge, this work experiment reports, for the first time, that volatile compounds produced by M. anisopliae possess antifungal activity. The volatile organic compounds produced by M. anisopliae also act as repellents against insects such as Macrotermes michaelseni [44], suggesting the M. anisopliae has the potential to be developed as a fumigant to control both plant diseases and insects. However, whether the substances play roles in antifungal activity in the volatile organic compounds requires further study.
4. Materials and Methods
4.1. Fungal Isolates and Cultural Condition
M. anisopliae strain IBCCM321.93 used in this study was the same as that used in the previous report [45]. M. anisopliae was cultured on potato dextrose agar (PDA) medium at 28 °C for 2 weeks.
B. cinerea strain B05.10 was incubated at 20 °C on PDA in the dark for 3 to 4 days to determine radial growth rates and for 20 days to determine sclerotia production [46]. The conidia of this strain were produced following a modified method that was described in the previous report [47,48]. Fifteen days post-incubation (dpi) on PDA medium, the conidia were harvested by flooding the plate with sterile water (plus 0.5% Tween 80, Xilong Scientific Co., Ltd., Guangdong, China), and the required conidia concentration was adjusted with hematocytometer.
4.2. Assay Inhibitory Effect of M. anisopliae
The inhibitory effect of M. anisopliae against B. cinerea was detected using a dual culture technique on the PDA plate. One mycelial plug (6 mm diameter) of M. anisopliae was placed on a new PDA plate 1 cm away from the border of every petri dish, and this was incubated at 28 °C for two days. Then, a mycelial plug (6 mm diameter) of B. cinerea derived from the edge of the vigorously growing colony was put on the other side of the plate. All plates with M. anisopliae and B. cinerea were incubated at 20 °C for 4 days until a clear inhibition zone was quantified. The trial was repeated three times with three replications. Inhibition of the pathogen development was assessed by means of the formula IG (%) = (BCK − BCF)/BCK × 100%, where IG denotes the growth of inhibition, BCK indicates the colony width in the control, and BCF indicates the colony width after treatment with culture filtrate, respectively [49].
4.3. Preparation of the Culture Filtrate of M. anisopliae
One block of a 14-day-old M. anisopliae mycelia plug (5 mm diameter) was inoculated in 250 mL conical flasks containing 100 mL of potato dextrose broth (PDB) (pH 6 to 6.5) and cultured in a shaker for 10 days at 160 rpm and 28 °C. Then, the fermented broth was centrifuged at room temperature at 12,000 rpm for 15 min to remove the mycelium. Then, the supernatant fraction was passed through sterile gauze cloth. The culture filtrate was collected after the supernatant passed through a 0.22 μm membrane filter (Millipore Sigma, USA).
4.4. Effect of M. anisopliae Culture Filtrate against the Growth of B. cinerea
B. cinerea was cultured on PDA and maintained at 20 °C in the dark. Petri dishes with PDA and culture filtrate of M. anisopliae were used to assess the effects of culture filtrate upon the radial growth of B. cinerea. In the treatment, the final concentrations of the culture filtrate (10%, 5%, 2%, and 1% (v/v)) were added PDA, whereas sterile PDB mixed with PDA served as a control. A three-day-old mycelial plug (5 mm in diameter) of B. cinerea was put in the middle of each petri dish and incubated at 20 °C. Each treatment set had three replications. Four days after incubation, the colony diameter of every dish was recorded in two vertical directions, and the growth inhibition (IG) of B. cinerea by the culture filtrate of M. anisopliae was calculated using the formula IG = [(mean of colony diameter in control – mean of colony diameter in treatment)/mean of colony diameter in control] × 100 [50]. The experiment was conducted three times.
4.5. Effect of Culture Filtrate of M. anisopliae against the Germination of Conidia and Sclerotia of B. cinerea
The inhibitory impacts of the culture filtrate of M. anisopliae on the germination of conidia, as well as the germ tube development of B. cinerea were tested using the procedures described in a previous report [51]. Germination of conidia was confirmed if the germ tube length was equivalent to or larger than the conidia [52]. The final concentration of the culture filtrate (1%, 2%, 5%, and 10%) was attained with sterile PDB. Fifteen microliters of the distinct dilutions were mixed with 3 µL of B. cinerea conidia suspension dosed at 5 × 105 conidia/mL and placed upon a glass slide. Sterilized PDB served as a control instead of culture filtrate. All slides were put into Petri dishes containing moist blotter paper to retain an elevated relative humidity. Then, they were incubated under white radiant light in an evolution chamber at 20 °C for 8 h. Germinated conidia were counted by microscope observation (Olympus CX41, Japan), and the germ tube length was measured. Afterwards, the germination inhibition percentage of conidia was calculated following the method of Youssef et al. [53]. For all treatments, at least 300 conidia were observed to determine the germination percentage, and 50 conidia were used for germ tube dimension when more than 90% of B. cinerea conidia in the PDB control were germinated after 8 h of incubation. This experiment was performed twice with three replications. B. cinerea was cultured on PDA at 20 °C for 21 d. To test the influence of M. anisopliae on the sclerotia germination of B. cinerea, black matured sclerotia were used in the assay following the method described by Yang et al. [54]. The surface-sterilized sclerotia were dipped in a 10% (v/v) culture filtrate of M. anisopliae for 24 h, before being air-dried and placed into PDA plates. Every treatment was conducted three times with 50 deliberate sclerotia in each treatment. All PDA plates containing sclerotia were incubated at 20 °C for 2 days. Germinated sclerotia were counted in the control and treated groups, and then sclerotia germination rates were calculated.
4.6. Effect of Culture Filtrate of M. anisopliae on the Plasma Membrane Integrity of B. cinerea Conidia
The conidia concentration of B. cinerea (1 × 106 conidia/mL) was incubated in a 10% culture filtrate of M. anisopliae at 20 °C without shaking. Sterile distilled water was used instead of culture filtrate in the negative control. After 2, 4, 6, and 8 h of incubation, conidia specimens were centrifuged at 10,000 rpm. Subsequently, staining and inspections of conidia were performed, as described previously [4]. Concisely, the conidia were dyed in 10 μg/mL of propidium iodide (Sigma-Aldrich, USA) for five min at room temperature and then centrifuged. The conidia pellets were rinsed twice with PBS buffer (pH 7.0). Inspections were conducted with a Nikon Eclipse 80i microscope (Japan) fitted with epifluorescence optics using blue excitation (450 to 490 nm) and 526 nm barrier filters. A total of 300 conidia was checked arbitrarily to determine whether conidia were stained by the dye. Membrane veracity damage was calculated following the formula (MV = (number of total conidia – number of stained conidia)/(number of total conidia) × 100%). This experiment was performed three times.
4.7. Heat Stability of Culture Filtrate Activity of M. anisopliae
To investigate the heat stability of culture filtrate, it was exposed to different temperatures (40, 60, 80, and 100 °C) for 15 min. After exposure to heat, culture filtrate of M. anisopliae was promptly cooled to room temperature, and its antagonistic activity was assessed against B. cinerea. The inhibitory effects of the heat-treated 5% culture filtrates on the radial growth of B. cinerea was determined, as described in Section 4.4. This experiment was repeated twice.
4.8. Sample Preparation for Transmission Electron Microscopy
The effect of M. anisopliae culture filtrate on the cell components of B. cinerea mycelia was examined with transmission electron microscopy (TEM). The mycelial morphology of B. cinerea was examined following the method described by Zhang with appropriate modifications [55]. Briefly, the sterilized cellophane sheets were set on PDA with 5% culture filtrate of M. anisopliae, and PDA plates without culture filtrate were set as the control. Then, three-day-old culture mycelial plugs of B. cinerea were inoculated on each plate and cultured at 20 °C for 4 days. Afterwards, the colonized cellophane sheets were sliced into 2 × 3 mm units with a sharp blade. The small units of cellophane sheet were fixed in Karnovsky’s fixative (2% paraformaldehyde and 2.5% glutaraldehyde, (Polysciences, Inc., Warrington, PA) in 0.1 M MOPS buffer, pH 7.0) at 4 °C for 24 h, Then, they were washed in MOPS buffer (pH 7.0, MOPS stands 3-[N-morpholino]propane-sulphonic acid, Sigma- Aldrich, USA) three to four times at 25 °C for 10 min, fixed in 1% osmium tetroxide (Anilax Chemicals Inc. USA) for 2 h, and dyed in 5% (w/v) uranyl acetate (Thomas Scientific, USA) in 50% (v/v) ethanol for 1 h. Subsequently, the affixed mycelial samples were desiccated in 30% ethanol for 15 min, 50% ethanol for 15 min, 70% ethanol for 15 min, 80% ethanol for 20 min, 90% ethanol for 20 min, and 100% ethanol for 30 min. Then, 100% acetone was used to dehydrate samples twice, for 30 min each time. Next, samples were embedded with SPI-Pon 812 embedding kit (SPI Supplies, USA), along with polymerization at 60 °C for 12 h. Thin slices (50 to 60 nm) were cut with an ultra-microtome, mounted on copper grids, stained with 2% uranyl acetate and 5% aqueous lead citrate, and examined with a FEI Tecnai G2 transmission electron microscope at 75 kV acceleration voltage. Images were recorded with a 4 KCCD camera (Model, 832 ORIUS, Gatan, Pleasanton, CA, USA).
4.9. Effect of Culture Filtrate on Gray Mold on Detached Tomato Leaves
Healthy tomato leaves were collected from five-week-old plants (Lycopersicon esculentum cv. Mill) and surfaces were disinfected by soaking in a 1% NaClO solution for 2 min (Sino-pharm Chemical Reagent Co., Ltd., Shanghai, China). Then, leaves were thoroughly washed with sterilized, distilled water and dried naturally. Whole leaves were soaked in 10% culture filtrate for 30 min and dried inside a laminar airflow. Subsequently, sterile water soak, instead of culture filtrate, was used as control. After drying the detached leaves’ surfaces, 15 μL of B. cinerea conidia suspension (1 × 106 conidia/ml) in 0.5% Tween 80 comprising 1 mg/mL of sucrose was dripped for inoculation. Each detached leaf was incubated inside the incubator at 20 °C along with the white light. Four days after incubation, lesion diameters were measured, and the biocontrol efficacy of M. anisopliae was calculated as (lesion diameter in the control − lesion diameter in the treatment)/lesion diameter in the control × 100 [56]. This experiment was performed twice.
4.10. Effect of Culture Filtrate of M. anisopliae on the Gray Mold of Ripe Tomato Fruits
In this assay, ripe tomato fruits were infected as described in [57]. Mature, red, rot-free tomato fruits, even in size and injury, were used in the gray mold biocontrol assays. The surfaces of the ripe tomatoes were sterilized with 1% (w/v) NaClO solution for 2 min, and then washed with water and naturally dried. Disinfected tomato fruits were wounded (2 mm depth and 2 mm in diameter) by forceps. Then, 30 μL of 10% culture filtrate of M. anisopliae, or sterile PDB instead of culture filtrate as the control, was placed into the wounds. Approximately two hours after treatment, 15 μL of B. cinerea conidia (1 × 106 conidia/ml) suspension was inserted into each wound. All tomato fruits were put on moist absorbent paper in plastic cases to retain a high level of humidity, and these were incubated at 20 °C. The lesion diameters of the infected tomato fruits were measured after 4 days of incubation in accordance with Liu et al. [58]. Every treatment comprised 10 tomatoes, and the trial was conducted twice.
4.11. Effect of Culture Filtrate of M. anisopliae against Tomato Plant Gray Mold
Tomato seeds (Lycopersicon esculentum cv. Mill) were sown in vermiculite soil and transplanted after two weeks in an individual pot containing potting mix soil. Plants were cultured in the greenhouse for 6 weeks. Afterwards, each leaf of five leaflets was sprayed with 10% culture filtrate until overflow 4 h prior to inoculation with B. cinerea conidia. Leaflets sprayed with 10% PDB medium served as a control. Subsequently, 25 leaves per plant were inoculated with 15 µL of conidial suspension (in 1% sucrose solution containing 0.1% Tween 80), and 0.1% Tween 80 containing sterile distilled water was used as a control. Two B. cinerea conidia concentrations (1 × 106 and 5 × 106 conidia/mL) were used for inoculation in the assays. The experimental plants were organized in a complete randomized block design with two replicates of three plants for each treatment. After 4 days of inoculation with B. cinerea conidia, the gray mold incidence was recorded. The biocontrol efficacy was estimated using the gray mold infection of detached leaves, as previously mentioned.
4.12. Volatile Effect of M. anisopliae on B. cinerea
A M. anisopliae mycelium plug (6 mm diameter) was placed on a PPDA (potato peptone dextrose agar; 200 g potato juice, 10 g peptone, 20 g dextrose, and 15 g agar in 1 liter) plate and cultured at 28 °C. Seven days later, the petri dish containing M. anisopliae was covered by another B. cinerea inoculated PDA plate, and two plates were sealed with parafilm to get a double-plate chamber [19]. A B. cinerea inoculated PDA plate covered with a fresh PPDA plate served as the control. Double plates were incubated in a growth chamber at 20 °C. Four days after incubation, the B. cinerea colony diameters were measured in treated and control treatments, and the inhibition percentage of radial growth was assessed. For each treatment, three replicates and three repeats were performed.
4.13. Effect of M. anisopliae VOCs on Botrytis Gray Mold of Postharvest Tomatoes
The assay was conducted in sealed glass desiccators following the method described by Huang et al. [59]. M. anisopliae was cultured on PPDA at 28 °C for 7 days. The lids of plates with M. anisopliae were removed, and then one plate (16 cm) was positioned at the bottom, and three plates (9 cm) were vertically positioned on the pierced ceramic board of each desiccator. For the control treatment, uncovered PPDA plates without strains were placed in the desiccator. Surface sterilized healthy tomatoes were wounded (2 × 2 mm, depth and diameter) with sterile forceps, inoculated with 15 μL of B. cinerea conidial suspension (1 × 106 conidia/mL), and put on the pierced ceramic clapboard in the desiccator. All inoculated tomatoes containing desiccators were independently covered with a lid and kept at 20 °C. The lesion diameter of the infected tomatoes was measured 4 days after incubation, in accordance with Liu et al [58]. Nine tomato fruits were used in each treatment, and the trial was conducted twice.
4.14. Data Analysis
Data were statistically analyzed with a one-way analysis of variance (ANOVA) using SAS software (SAS Institute, Cary, NC, USA, v. 8.1, 1999). The data are expressed as means ± standard error (SE). Treatment means were partitioned using the least significant difference (LSD) test at P < 0.01.
5. Conclusions
In this research, it was found that, in addition to pest control ability, the entomopathogenic fungus M. anisopliae can inhibit B. cinerea mycelia growth, sclerotia formation and germination, and conidia germination. Additionally, both the culture filtrate and volatile compounds produced by M. anisopliae possess antifungal activity, and the culture filtrate retains its activity under high temperatures. The results of the present study indicate that M. anisopliae is a potential alternative to chemical fungicides for controlling B. cinerea on pre- and postharvest crops. However, a deeper understanding of the antifungal mechanism in relation to the structure–activity relationship of the active substance could be developed in more depth in the future. In addition, the potential of M. anisopliae biocontrol on other important plant pathogens could be tested in the future.
Author Contributions
Formal analysis, M.S.; Methodology, Q.H., J.D., F.Y., and X.X.; Resources, G.W. Software, Q.H.; Supervision, Y.X. and X.X.; Writing—original draft, M.S.; Writing—review & editing, Y.X. and X.X. All authors have read and agreed to the published version of the manuscript.
Funding
This research was funded by the National Natural Science Foundation of China, grant number 31501595, and the National Key R&D Program of China, grant number 2018YFD0201006.
Acknowledgments
We thank Professor Qiuying Huang and Professor Guoqing Li at the Huazhong Agricultural University for providing the Metarhizium anisopliae strain and Botrytis cinerea strain, respectively.
Conflicts of Interest
The authors declare no conflict of interest. The funders had no role in the design of the study; in the collection, analyses, or interpretation of data; in the writing of the manuscript, or in the decision to publish the results.
References
- Agrios, G. Botrytis diseases. In Plant Pathology, 5th ed.; Dreibelbis, D., Ed.; Elsevier Academic Press: San Diego, CA, USA, 2005; pp. 510–514. [Google Scholar]
- Williamson, B.; Tudzynski, B.; Tudzynski, P.; van Kan, J.A. Botrytis cinerea: The cause of grey mould disease. Mol. Plant Pathol. 2007, 8, 561–580. [Google Scholar] [CrossRef]
- Elad, Y.; Pertot, I.; Prado, A.M.C.; Stewart, A. Plant hosts of Botrytis spp. In Botrytis–The Fungus, the Pathogen and Its Management in Agricultural Systems; Springer: Berlin/Heidelberg, Germany, 2016; pp. 413–486. [Google Scholar]
- Wang, J.; Xia, X.-M.; Wang, H.-Y.; Li, P.-P.; Wang, K.-Y. Inhibitory effect of lactoferrin against gray mould on tomato plants caused by Botrytis cinerea and possible mechanisms of action. Int. J. Food Microbiol. 2013, 161, 151–157. [Google Scholar] [CrossRef] [PubMed]
- Hua, L.; Yong, C.; Zhanquan, Z.; Boqiang, L.; Guozheng, Q.; Shiping, T. Pathogenic mechanisms and control strategies of Botrytis cinerea causing post-harvest decay in fruits and vegetables. Food Qual. Saf. 2018, 2, 111–119. [Google Scholar] [CrossRef]
- Elad, Y.; Williamson, B.; Tudzynski, P.; Delen, N. Botrytis spp. and diseases they cause in agricultural systems–an introduction. In Botrytis: Biology, Pathology and Control; Springer: Berlin/Heidelberg, Germany, 2007; pp. 1–8. [Google Scholar]
- Ciliberti, N.; Fermaud, M.; Roudet, J.; Rossi, V. Environmental conditions affect Botrytis cinerea infection of mature grape berries more than the strain or transposon genotype. Phytopathology 2015, 105, 1090–1096. [Google Scholar] [CrossRef] [PubMed]
- Elmer, P.A.; Michailides, T.J. Epidemiology of Botrytis cinerea in orchard and vine crops. In Botrytis: Biology, Pathology and Control; Springer: Berlin/Heidelberg, Germany, 2007; pp. 243–272. [Google Scholar]
- Adnan, M.; Hamada, M.; Li, G.; Luo, C. Detection and molecular characterization of resistance to the dicarboximide and benzamide fungicides in Botrytis cinerea from tomato in Hubei Province, China. Plant Dis. 2018, 102, 1299–1306. [Google Scholar] [CrossRef]
- Myresiotis, C.; Karaoglanidis, G.; Tzavella-Klonari, K. Resistance of Botrytis cinerea isolates from vegetable crops to anilinopyrimidine, phenylpyrrole, hydroxyanilide, benzimidazole, and dicarboximide fungicides. Plant Dis. 2007, 91, 407–413. [Google Scholar] [CrossRef]
- Mosbach, A.; Edel, D.; Farmer, A.D.; Widdison, S.; Barchietto, T.; Dietrich, R.A.; Corran, A.; Scalliet, G. Anilinopyrimidine resistance in Botrytis cinerea is linked to mitochondrial function. Front. Microbiol. 2017, 8, 2361. [Google Scholar] [CrossRef]
- Adnan, M.; Hamada, M.S.; Hahn, M.; Li, G.-Q.; Luo, C.-X. Fungicide resistance of Botrytis cinerea from strawberry to procymidone and zoxamide in Hubei, China. Phytopathol. Res. 2019, 1, 17. [Google Scholar] [CrossRef]
- Kretschmer, M.; Leroch, M.; Mosbach, A.; Walker, A.-S.; Fillinger, S.; Mernke, D.; Schoonbeek, H.-J.; Pradier, J.-M.; Leroux, P.; De Waard, M.A. Fungicide-driven evolution and molecular basis of multidrug resistance in field populations of the grey mould fungus Botrytis cinerea. PLoS Pathog. 2009, 5, e1000696. [Google Scholar] [CrossRef]
- Rosero-Hernández, E.D.; Moraga, J.; Collado, I.G.; Echeverri, F. Natural compounds that modulate the development of the fungus Botrytis cinerea and protect Solanum lycopersicum. Plants 2019, 8, 111. [Google Scholar] [CrossRef]
- Abbey, J.A.; Percival, D.; Abbey, L.; Asiedu, S.K.; Prithiviraj, B.; Schilder, A. Biofungicides as alternative to synthetic fungicide control of grey mould (Botrytis cinerea)–prospects and challenges. Biocontrol. Sci. Technol. 2019, 29, 207–228. [Google Scholar] [CrossRef]
- Aqueveque, P.; Céspedes, C.L.; Becerra, J.; Aranda, M.; Sterner, O. Antifungal activities of secondary metabolites isolated from liquid fermentations of Stereum hirsutum (Sh134-11) against Botrytis cinerea (grey mould agent). Food Chem. Toxicol. 2017, 109, 1048–1054. [Google Scholar] [CrossRef] [PubMed]
- Kasfi, K.; Taheri, P.; Jafarpour, B.; Tarighi, S. Identification of epiphytic yeasts and bacteria with potential for biocontrol of grey mold disease on table grapes caused by Botrytis cinerea. Span. J. Agric. Res. 2018, 16, 1002. [Google Scholar] [CrossRef]
- Calvo-Garrido, C.; Roudet, J.; Aveline, N.; Davidou, L.; Dupin, S.; Fermaud, M. Microbial antagonism toward Botrytis bunch rot of grapes in multiple field tests using one Bacillus ginsengihumi strain and formulated biological control products. Front. Plant Sci. 2019, 10. [Google Scholar] [CrossRef]
- Mulero-Aparicio, A.; Cernava, T.; Turra, D.; Schaefer, A.; Pietro, A.D.; Escudero, F.J.L.; Trapero, A.; Berg, G. The role of volatile organic compounds and rhizosphere competence in the mode of action of the non-pathogenic Fusarium oxysporum FO12 towards Verticillium wilt. Front. Microbiol. 2019, 10, 1808. [Google Scholar] [CrossRef]
- Chen, X.; Wang, Y.; Gao, Y.; Gao, T.; Zhang, D. Inhibitory abilities of Bacillus isolates and their culture filtrates against the gray mold caused by Botrytis cinerea on postharvest fruit. Plant Pathol. J. 2019, 35, 425. [Google Scholar]
- Köhl, J.; Kolnaar, R.; Ravensberg, W.J. Mode of action of microbial biological control agents against plant diseases: Relevance beyond efficacy. Front. Plant Sci. 2019, 10, 845. [Google Scholar] [CrossRef]
- Mhlongo, M.I.; Piater, L.A.; Madala, N.E.; Labuschagne, N.; Dubery, I.A. The chemistry of plant–microbe interactions in the rhizosphere and the potential for metabolomics to reveal signaling related to defense priming and induced systemic resistance. Front. Plant Sci. 2018, 9, 112. [Google Scholar] [CrossRef]
- Kassa, A.; Stephan, D.; Vidal, S.; Zimmermann, G. Production and processing of Metarhizium anisopliae var. acridum submerged conidia for locust and grasshopper control. Mycol. Res. 2004, 108, 93–100. [Google Scholar] [CrossRef]
- Abdel-Raheem, M.; Al-Keridis, L.A. Virulence of three entomopathogenic fungi against whitefly, Bemisia tabaci (Gennadius) (Hemiptera: Aleyrodidae) in tomato crop. J. Entomol. 2017, 14, 155–159. [Google Scholar]
- Kivett, J.; Cloyd, R.; Bello, N. Evaluation of entomopathogenic fungi against the western flower thrips (Thysanoptera: Thripidae) under laboratory conditions. J. Entomol. Sci. 2016, 51, 274–291. [Google Scholar] [CrossRef]
- Nardoni, S.; Ebani, V.V.; D’Ascenzi, C.; Pistelli, L.; Mancianti, F. Sensitivity of entomopathogenic fungi and bacteria to plants secondary metabolites, for an alternative control of Rhipicephalus (Boophilus) microplus in cattle. Front. Pharmacol. 2018, 9, 937. [Google Scholar] [CrossRef] [PubMed]
- Jaber, L.R.; Ownley, B.H. Can we use entomopathogenic fungi as endophytes for dual biological control of insect pests and plant pathogens? Biol. Control 2018, 116, 36–45. [Google Scholar] [CrossRef]
- Gao, Q.; Jin, K.; Ying, S.-H.; Zhang, Y.; Xiao, G.; Shang, Y.; Duan, Z.; Hu, X.; Xie, X.-Q.; Zhou, G. Genome sequencing and comparative transcriptomics of the model entomopathogenic fungi Metarhizium anisopliae and M. acridum. PLoS Genet. 2011, 7, e1001264. [Google Scholar] [CrossRef]
- Vyas, N.; Dua, K.; Prakash, S. Larvicidal activity of metabolites of Metarhizium anisopliae against aedes and culex mosquitoes. Entomol. Ornithol. Herpetol. 2015, 4, 1. [Google Scholar] [CrossRef]
- Isaka, M.; Kittakoop, P.; Kirtikara, K.; Hywel-Jones, N.L.; Thebtaranonth, Y. Bioactive substances from insect pathogenic fungi. Acc. Chem. Res. 2005, 38, 813–823. [Google Scholar] [CrossRef]
- Yun, H.-G.; Kim, D.-J.; Gwak, W.-S.; Shin, T.-Y.; Woo, S.-D. Entomopathogenic fungi as dual control agents against both the pest Myzus persicae and phytopathogen Botrytis cinerea. Mycobiology 2017, 45, 192–198. [Google Scholar] [CrossRef]
- Shin, T.Y.; Bae, S.M.; Woo, S.D. Screening and characterization of antimicrobial substances originated from entomopathogenic fungi. J. Asia Pac. Entomol. 2016, 19, 1053–1059. [Google Scholar] [CrossRef]
- Dean, R.; Van Kan, J.A.; Pretorius, Z.A.; Hammond-Kosack, K.E.; Di Pietro, A.; Spanu, P.D.; Rudd, J.J.; Dickman, M.; Kahmann, R.; Ellis, J. The Top 10 fungal pathogens in molecular plant pathology. Mol. Plant Pathol. 2012, 13, 414–430. [Google Scholar] [CrossRef]
- Vos, C.M.; De Cremer, K.; Cammue, B.P.; De Coninck, B. The toolbox of Trichoderma spp. in the biocontrol of Botrytis cinerea disease. Mol. Plant Pathol. 2015, 16, 400–412. [Google Scholar] [CrossRef]
- Paulitz, T.C.; Bélanger, R.R. Biological control in greenhouse systems. Annu. Rev. Phytopathol. 2001, 39, 103–133. [Google Scholar] [CrossRef] [PubMed]
- Jaber, L.R. Seed inoculation with endophytic fungal entomopathogens promotes plant growth and reduces crown and root rot (CRR) caused by Fusarium culmorum in wheat. Planta 2018, 248, 1525–1535. [Google Scholar] [CrossRef] [PubMed]
- Schrank, A.; Vainstein, M.H. Metarhizium anisopliae enzymes and toxins. Toxicon 2010, 56, 1267–1274. [Google Scholar] [CrossRef] [PubMed]
- Freimoser, F.M.; Hu, G.; St Leger, R.J. Variation in gene expression patterns as the insect pathogen Metarhizium anisopliae adapts to different host cuticles or nutrient deprivation in vitro. Microbiology 2005, 151, 361–371. [Google Scholar] [CrossRef] [PubMed]
- Baek, J.-M.; Howell, C.R.; Kenerley, C.M. The role of an extracellular chitinase from Trichoderma virens Gv29-8 in the biocontrol of Rhizoctonia solani. Curr. Genet. 1999, 35, 41–50. [Google Scholar] [CrossRef] [PubMed]
- Limón, M.; Chacón, M.; Mejías, R.; Delgado-Jarana, J.; Rincón, A.; Codón, A.; Benítez, T. Increased antifungal and chitinase specific activities of Trichoderma harzianum CECT 2413 by addition of a cellulose binding domain. Appl. Microbiol. Biotechnol. 2004, 64, 675–685. [Google Scholar] [CrossRef]
- Viterbo, A.; Haran, S.; Friesem, D.; Ramot, O.; Chet, I. Antifungal activity of a novel endochitinase gene (chit36) from Trichoderma harzianum Rifai TM. FEMS Microbiol. Lett. 2001, 200, 169–174. [Google Scholar] [CrossRef]
- Wu, Q.; Bai, L.; Liu, W.; Li, Y.; Lu, C.; Li, Y.; Fu, K.; Yu, C.; Chen, J. Construction of a Streptomyces lydicus A01 transformant with a chit42 gene from Trichoderma harzianum P1 and evaluation of its biocontrol activity against Botrytis cinerea. J. Microbiol. 2013, 51, 166–173. [Google Scholar] [CrossRef]
- Sbaraini, N.; Guedes, R.L.M.; Andreis, F.C.; Junges, Â.; de Morais, G.L.; Vainstein, M.H.; de Vasconcelos, A.T.R.; Schrank, A. Secondary metabolite gene clusters in the entomopathogen fungus Metarhizium anisopliae: Genome identification and patterns of expression in a cuticle infection model. BMC Genom. 2016, 17, 736. [Google Scholar] [CrossRef]
- Mburu, D.M.; Ndung’u, M.W.; Maniania, N.K.; Hassanali, A. Comparison of volatile blends and gene sequences of two isolates of Metarhizium anisopliae of different virulence and repellency toward the termite Macrotermes michaelseni. J. Exp. Biol. 2011, 214, 956–962. [Google Scholar] [CrossRef][Green Version]
- Liu, L.; Li, G.; Sun, P.; Lei, C.; Huang, Q. Experimental verification and molecular basis of active immunization against fungal pathogens in termites. Sci. Rep. 2015, 5, 15106. [Google Scholar] [CrossRef] [PubMed]
- Zhou, Y.; Li, N.; Yang, J.; Yang, L.; Wu, M.; Chen, W.; Li, G.; Zhang, J. Contrast between orange-and black-colored sclerotial isolates of Botrytis cinerea: Melanogenesis and ecological fitness. Plant Dis. 2018, 102, 428–436. [Google Scholar] [CrossRef] [PubMed]
- Potgieter, C.A.; Castillo, A.; Castro, M.; Cottet, L.; Morales, A. A wild-type Botrytis cinerea strain co-infected by double-stranded RNA mycoviruses presents hypovirulence-associated traits. Virol. J. 2013, 10, 220. [Google Scholar] [CrossRef] [PubMed]
- Yu, L.; Sang, W.; Wu, M.-D.; Zhang, J.; Yang, L.; Zhou, Y.-J.; Chen, W.-D.; Li, G.-Q. Novel hypovirulence-associated RNA mycovirus in the plant-pathogenic fungus Botrytis cinerea: Molecular and biological characterization. Appl. Environ. Microbiol. 2015, 81, 2299–2310. [Google Scholar] [CrossRef] [PubMed]
- Singh, D.; Singh, R.; Salisbury, P.; Barbetti, M. Genetic diversity in Australian, Indian and Chinese oilseed Brassica germplasm against sclerotinia-rot resistance. In Proceedings of the International Rapeseed Congress, Prague, Crech Republic, 5–9 June 2011. [Google Scholar]
- Shakeel, Q.; Lyu, A.; Zhang, J.; Wu, M.; Li, G.; Hsiang, T.; Yang, L. Biocontrol of Aspergillus flavus on peanut kernels using Streptomyces yanglinensis 3–10. Front. Microbiol. 2018, 9, 1049. [Google Scholar] [CrossRef]
- Boukaew, S.; Prasertsan, P.; Troulet, C.; Bardin, M. Biological control of tomato gray mold caused by Botrytis cinerea by using Streptomyces spp. Biocontrol 2017, 62, 793–803. [Google Scholar] [CrossRef]
- Vicedo, B.; de la O Leyva, M.; Flors, V.; Finiti, I.; Del Amo, G.; Walters, D.; Real, M.D.; García-Agustín, P.; González-Bosch, C. Control of the phytopathogen Botrytis cinerea using adipic acid monoethyl ester. Arch. Microbiol. 2006, 184, 316–326. [Google Scholar] [CrossRef]
- Youssef, K.; Roberto, S.R.; de Oliveira, A.G. Ultra-structural alterations in Botrytis cinerea—the causal agent of gray mold—treated with salt solutions. Biomolecules 2019, 9, 582. [Google Scholar] [CrossRef]
- Yang, F.; Abdelnabby, H.; Xiao, Y. A mutant of the nematophagous fungus Paecilomyces lilacinus (Thom) is a novel biocontrol agent for Sclerotinia sclerotiorum. Microb. Pathog. 2015, 89, 169–176. [Google Scholar] [CrossRef]
- Kang, Z. Ultrastructure of Plant Pathogenic Fungi; China Science & Technology Press: Beijing, China, 1996. [Google Scholar]
- Wang, S.; Ruan, C.; Yi, L.; Deng, L.; Yao, S.; Zeng, K. Biocontrol ability and action mechanism of Metschnikowia citriensis against Geotrichum citri-aurantii causing sour rot of postharvest citrus fruit. Food Microbiol. 2020, 87, 103375. [Google Scholar] [CrossRef]
- Gao, P.; Qin, J.; Li, D.; Zhou, S. Inhibitory effect and possible mechanism of a Pseudomonas strain QBA5 against gray mold on tomato leaves and fruits caused by Botrytis cinerea. PLoS ONE 2018, 13, e0190932. [Google Scholar] [CrossRef] [PubMed]
- Liu, Y.; Yao, S.; Deng, L.; Ming, J.; Zeng, K. Different mechanisms of action of isolated epiphytic yeasts against Penicillium digitatum and Penicillium italicum on citrus fruit. Postharvest Biol. Technol. 2019, 152, 100–110. [Google Scholar] [CrossRef]
- Huang, R.; Li, G.; Zhang, J.; Yang, L.; Che, H.; Jiang, D.; Huang, H. Control of postharvest Botrytis fruit rot of strawberry by volatile organic compounds of Candida intermedia. Phytopathology 2011, 101, 859–869. [Google Scholar] [CrossRef] [PubMed]
© 2020 by the authors. Licensee MDPI, Basel, Switzerland. This article is an open access article distributed under the terms and conditions of the Creative Commons Attribution (CC BY) license (http://creativecommons.org/licenses/by/4.0/).